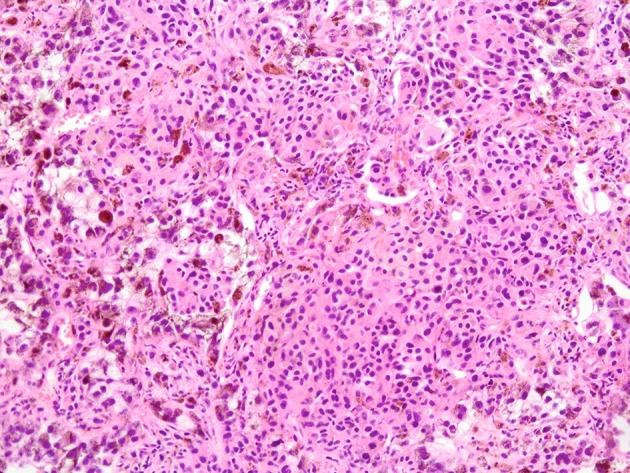

恶性黑色素瘤自发性肿瘤溶解综合征1例
A Case of Spontaneous Tumor Lysis Syndrome in Malignant Melanoma.
作者信息
Takeuchi Nobumichi, Miyazawa Shun, Ohno Zentaro, Yoshida Sonomi, Tsukamoto Tetsu, Fujiwara Masayuki
机构信息
Department of Medical Oncology, Ina Central Hospital, 1313-1 Koshirou-Kubo, Ina-city, Nagano 396-8555, Japan.
Department of Pathology, Tokyo Medical University Hachiouji Medical Center, 1163 Tatemachi, Hachiouji, Tokyo 193-0998, Japan.
出版信息
World J Oncol. 2016 Jun;7(2-3):40-44. doi: 10.14740/wjon970w. Epub 2016 Jul 1.
A 62-year-old man with a complaint of back pain lasting 2 months was admitted. He also presented a huge abdominal tumor. Diagnostic imaging showed metastatic tumors in the liver, lumbar vertebrae and bilateral lung. An ultrasound-guided needle biopsy revealed a lung tumor containing melanic tissue. Subsequently, there was an evident elevation in uric acid, phosphoric acid, potassium and lactate dehydrogenase concentrations in serum. Continuous hemodiafiltration and administration of rasburicase was initiated following the diagnosis of tumor lysis syndrome (TLS). However, he died on the fourth day owing to arrhythmia. An autopsy revealed metastatic deposits in the liver, lung, spine, ribs, and lymph nodes along the biliary system. Microscopic examinations revealed massive necrosis of normal hepatocytes and tumor cells with disseminated tumor thrombi in the portal system. The catastrophic progression of TLS appears to be influenced by a persistent portal blood flow deficiency by portal tumor thrombus in this case.
一名62岁男性因背痛持续2个月入院。他还出现了一个巨大的腹部肿瘤。诊断性影像学检查显示肝脏、腰椎和双侧肺有转移性肿瘤。超声引导下针吸活检显示肺部肿瘤含有黑色素组织。随后,血清尿酸、磷酸、钾和乳酸脱氢酶浓度明显升高。诊断为肿瘤溶解综合征(TLS)后开始持续血液透析滤过并给予拉布立酶。然而,他在第四天因心律失常死亡。尸检发现肝脏、肺、脊柱、肋骨和沿胆道系统的淋巴结有转移性沉积物。显微镜检查显示正常肝细胞和肿瘤细胞大量坏死,门静脉系统有弥漫性肿瘤血栓。在这种情况下,TLS的灾难性进展似乎受到门静脉肿瘤血栓导致的持续性门静脉血流不足的影响。